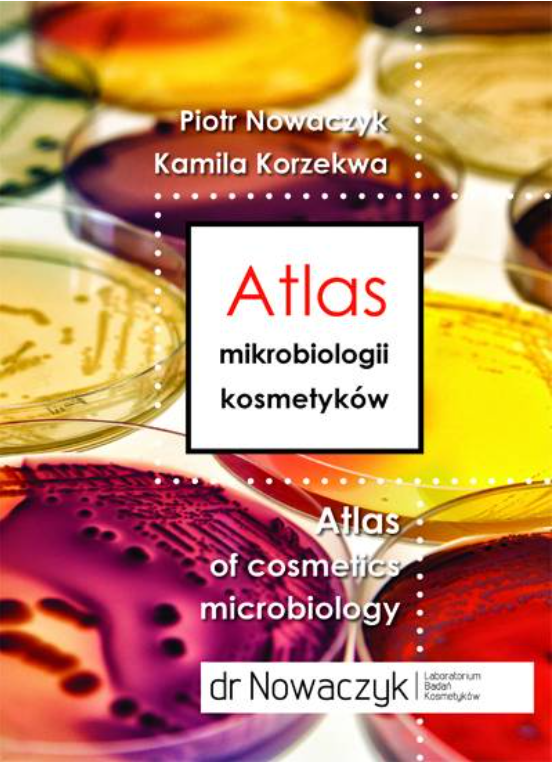

Newsletter 29.12.2022
W Łodzi ma powstać największy terminal intermodalny w PolsceGrupa Geodis planuje nową inwestycję, dzięki której jej terminal zyska status największego intermodalnego terminala śródlądowego w Polsce i jednego z największych tego typu obiektów pod względem możliwości przeładunkowych w Europie.
Firmy energetyczne myślą o biogazowanichPaństwowe spółki energetyczne zaczynają planować rozwijanie projektów budowy biogazowni.
Zachodnie Pomorze chce rozwijać gospodarkę wodorowąZachodniopomorskie chce tworzyć podstawy do rozwoju gospodarki wodorowej w Polsce. Działające tam firmy: Grupa Azoty S.A., Grupa Azoty Zakłady Chemiczne Police, Grupa Azoty Polyolefins, Port Morski Police, Enea S.A, Enea Operator, a także instytucje publiczne i naukowe znalazły się w gronie sygnatariuszy listu intencyjnego na rzecz budowy Zachodniopomorskiej Doliny Wodorowej. Tym samym strony wyraziły wolę nawiązania współpracy i podjęcia działań zmierzających do budowy i rozwoju gospodarki wodorowej, ze szczególnym uwzględnieniem województwa zachodniopomorskiego.
Grupa Azoty coraz bliżej inwestycji w fotowoltaikęGrupa Azoty ustaliła kluczowe warunki transakcji dotyczącej nabycia 100% udziałów w kapitale zakładowym Solarfarm Brzezinka.
REKLAMA
Polecamy nasze pozycje książkowe!
1. Książka "Surfaktanty (środki powierzchniowo czynne) i ich zastosowanie w produktach kosmetycznych" stanowi kompendium wiedzy na temat budowy i właściwości surfaktantów oraz ich zastosowania w chemii kosmetycznej. Oprócz omówienia poszczególnych grup środków powierzchniowo czynnych zawiera także charakterystykę najczęściej stosowanych spc ze wskazaniem działania kosmetycznego i ich roli w formie.
Dowiedż się więcej >>>
2. Książka „Surowce i formy kosmetyczne. Tom 2. Zagęstniki (modyfikatory reologii) w produktach kosmetycznych" autorstwa Beaty W. Domagalskiej. Książka dotyczy znanej szeroko dziedziny, jaką są środki higieny, upiększające, myjące, stylizujące, czyli związana jest z problemami codziennego życia.
Zapraszamy do naszego sklepu >>>
3. „Atlas mikrobiologii kosmetyków” autorstwa Piotra Nowaczyka i Kamili Korzekwy. Atlas jest pierwszym jak do tej pory na polskim i europejskim rynku wydawniczym praktycznym kompendium wiedzy z zakresu mikrobiologii kosmetyków.
Link do sklepu internetowego >>>
Organizacje branżowe krytykują unijną legislację względem opakowań60 europejskich organizacji branżowych z łańcucha wartości opakowań wydało wspólne oświadczenie odnoszące się do zaproponowanej przez Komisję Europejską rewizji przepisów dotyczących opakowań i odpadów opakowaniowych. Przemysł wzywa do uznania kluczowej roli recyklingu w osiągnięciu obiegu zamkniętego opakowań; ustanowienia jasnych ram umożliwiających obowiązkowe zbieranie i recykling przy jednoczesnym zwiększaniu ponownego napełniania i ponownego użycia; wykreowania środowiska do znacznego zwiększenia inwestycji w infrastrukturę sortowania i recyklingu oraz wzywa do zachowania funkcjonalności opakowania i bezpieczeństwa produktu.
Fundusz PKN Orlen inwestuje w katalizatory stosowane w reakcji metatezy olefinPKN Orlen planuje wdrożenie innowacyjnej technologii, która umożliwi tańsze, szybsze i bardziej ekologiczne wytworzenie półproduktów wykorzystywanych m.in. przy produkcji samochodów, leków, tworzyw sztucznych, czy też dodatków do paliw. W tym celu funduszu VC stworzony przez płocki koncern inwestuje w polską firmę Apeiron Synthesis.
Drony zbadały zakład CIECH w InowrocławiuSprawdzenie stanu infrastruktury, budynków, stawów odpadowych i szczelności kilkuset kilometrów sieci rurociągów, a także badanie jakości powietrza oraz inwentaryzacja składowisk węgla – to tylko niektóre zadania zrealizowane w fabryce CIECH w Inowrocławiu przez nowoczesne drony. Działania dostarczą spółce CIECH Soda Polska szczegółowych informacji na temat kondycji infrastruktury oraz stanu powietrza nad jej inowrocławską fabryką. Jednym z efektów oblotu dronów będzie trójwymiarowa mapa zakładu w Inowrocławiu. Analiza przy użyciu bezzałogowych statków powietrznych to jedno z pierwszych zastosowań tej techniki do inspekcji fabryk z sektora chemicznego w Polsce.